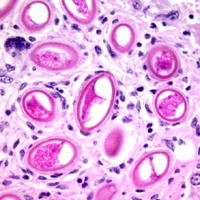
�����������������C���[�W

獣医病理学研修会は診断病理学の技術と知識の向上を目的に開催しています。
サービス/製品一覧研修会症例の記録 ARCHIVES
過去の病理研修会の記録

「過去の病理学研修会の記録 第58回まで」
第58回までの病理学研修会の記録は日生研で管理いただきました。下記のサイトにこれまでの記録を掲載してありますので確認ください。
なお、「日生研だより」への掲載は、2017年よりなくなりました。
第58回までの病理学研修会記録 https://jsvp.jp/kenshukai/
「第59回以降の病理学研修会の記録について」
第59回獣医病理学研修会より、症例の記録・記事をJCVPのホームページで管理することになりました。つきましては研修会で発表された症例の記事について、下記の原稿記載要領に従い原稿を作成いただき、指定された締め切り日(通常9月末日)までにJCVP事務局あるいはHP管理者まで送付ください。
原稿記載方法
標本番号、表題、提出機関を別にして、一出題症例あたり本文は、約1,000文字です。原則として、動物(動物種、品種、性別、年齢の順)、臨床症状、剖検所見、組織所見、診断、考察、参考文献に大別します。文章の最後に文責者を記載して下さい。テキスト保存したファイルをメールまたはCD-R等により提出ください。なお版権管理等の観点より図表は掲載いたしません。
獣医病理学研修会症例記録
「過去の症例記録」
・第59回(症例No.1220〜1243) こちらのページへ
・第60回(症例No.1244〜1267) こちらのページへ
・第61回(症例No.1268〜1292) こちらのページへ
・第62回(症例No.1293〜1316) こちらのページへ
・第63回(症例No.1317〜1341) こちらのページへ![]()
![]()
「過去の開催記録」PDF資料
第1回から第59回までの獣医病理学研修会の開催日程、症例No. 担当機関および開催地などに関する情報です。
「獣医病理学研修会開催記録および過去10年間の出題状況」(第1回〜59回) PDF